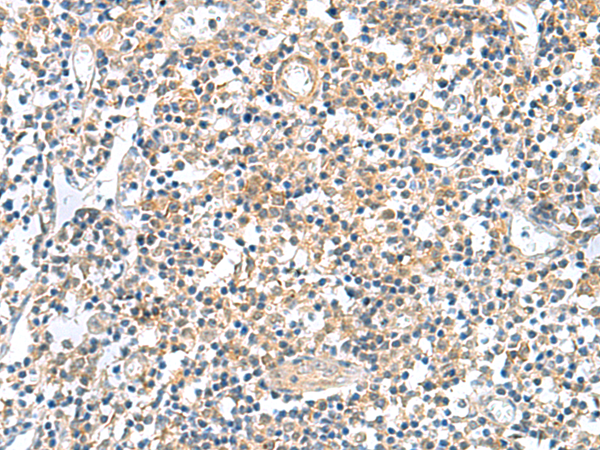

中文名稱:兔抗GEMIN7多克隆抗體
|
Background: |
The protein encoded by this gene is a component of the core SMN complex, which is required for pre-mRNA splicing in the nucleus. The encoded protein is found in the nucleoplasm, in nuclear "gems" (Gemini of Cajal bodies), and in the cytoplasm. Three transcript variants encoding the same protein have been found for this gene. |
|
Applications: |
ELISA, IHC |
|
Name of antibody: |
GEMIN7 |
|
Immunogen: |
Fusion protein of human GEMIN7 |
|
Full name: |
gem nuclear organelle associated protein 7 |
|
Synonyms: |
SIP3 |
|
SwissProt: |
Q9H840 |
|
ELISA Recommended dilution: |
5000-10000 |
|
IHC positive control: |
Human tonsil |
|
IHC Recommend dilution: |
50-200 |
購物車
幫助
021-54845833/15800441009
